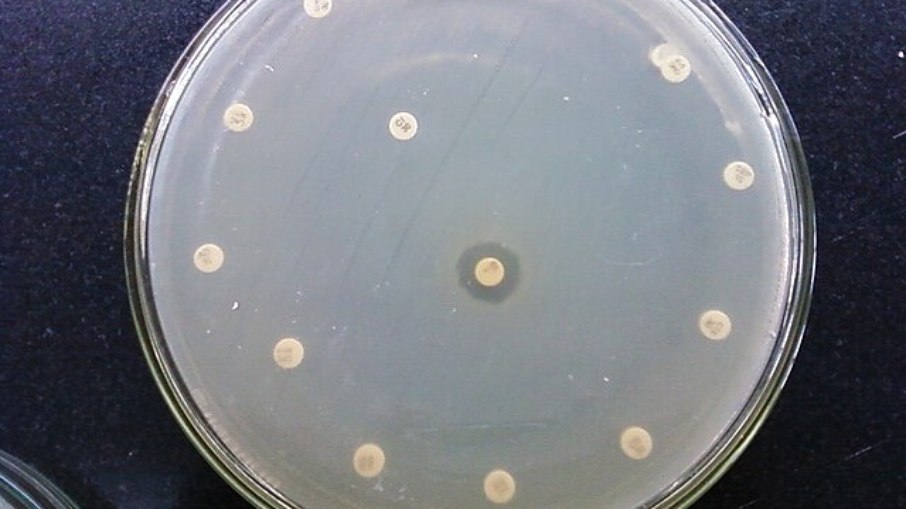
Superbactéria resistente a antibiótico

Um estudo publicado recentemente na Agência FAPESP identificou superbactérias em aves selvagens atendidas no Orquidário Municipal de Santos, no litoral paulista. De acordo com a pesquisa, os animais do centro de reabilitação apresentaram cepas de Escherichia coli (E. coli) resistentes a antibióticos.
Segundo os pesquisadores, esses organismos podem causar infecções graves em pessoas com o sistema imunológico fragilizado. Os quadros podem variar de uma simples infecção urinária até questões mais graves.
"Escherichia coli é uma bactéria comum do trato intestinal de muitos animais, inclusive nos humanos. Ela passa a ser um problema quando entra na corrente sanguínea ou causa infecções do trato urinário ou dos rins... Clones multirresistentes como esses frequentemente levam à morte" , explica Fábio Sellera, professor da Universidade Metropolitana de Santos (Unimes), à Agência FAPESP.
O que são superbactérias?
Em entrevista ao Portal iG, o médico infectologista Alexandre Naime explica que as superbactérias "são microrganismos que desenvolveram resistência a vários antibióticos que usamos habitualmente para tratar infecções".
"Isso significa que, diferentemente das bactérias comuns do dia a dia, que geralmente respondem bem aos tratamentos disponíveis, as superbactérias conseguem sobreviver e continuar causando doença mesmo diante de medicamentos que antes eram eficazes", pontua.

Dr. Alexandre Naime, médico e professor na UNESP e coordenador científico da Sociedade Brasileira de Infectologia
Naime adiciona que essa resistência não é algo que aparece de uma hora para outra. Para que ela ocorra, as bactérias precisam ser expostas repetidamente a antibióticos, "seja pelo uso sem prescrição, pela interrupção precoce do tratamento ou até mesmo pelo uso excessivo desses remédios em animais e na agricultura".
Naime diz que, como tornam algumas infecções mais difíceis de serem tratadas, as superbactérias representam um grande perigo, especialmente em situações clínicas. Elas podem causar pneumonias, infecções urinárias, de pele ou de corrente sanguínea, em que os antibióticos comuns já não fazem efeito. Com isso, surge a necessidade de terapias mais complexas, caras e com mais efeitos colaterais.
"Isso aumenta o tempo de internação, o risco de complicações e até a mortalidade em alguns casos. Além disso, o avanço dessas resistências limita o arsenal de antibióticos disponíveis, o que preocupa a comunidade médica mundial",
explica o especialista.
Vale lembrar, no entanto, que nem sempre a presença de uma superbactéria representa risco imediato. Segundo Naime, muitas vezes, esses microrganismos não causam doença ao colonizarem o corpo humano. Eles vivem em equilíbrio na pele, nas vias aéreas ou no intestino, sem sintomas nem necessidade de tratamento.
"O problema surge quando a pessoa está debilitada, imunossuprimida ou precisa passar por procedimentos médicos invasivos, que abrem portas para essas bactérias entrarem na circulação e causarem infecção. Assim, para a maioria das pessoas saudáveis, o risco é baixo, mas em ambientes hospitalares e em indivíduos vulneráveis, a ameaça é real e exige vigilância redobrada", diz.
Como evitar as superbactérias?
As superbactérias podem estar em qualquer lugar do cotidiano. No entanto, elas são mais comuns em hospitais e clínicas de saúde, onde o uso frequente de antibióticos e a presença de pacientes vulneráveis colaboram para a multiplicação dessas cepas resistentes, explica Naime.
"Também podem ser encontradas em superfícies de uso coletivo, em alimentos contaminados e até em animais, principalmente quando há uso excessivo de antibióticos na criação. No dia a dia das casas, podem estar em locais como banheiros e cozinhas, mas para pessoas saudáveis o risco de infecção costuma ser baixo",
explica.
Segundo o especialista, os cuidados para evitar as superbactérias são simples. No dia a dia, o mais importante é manter uma boa higiene das mãos, lavando com água e sabão sempre que possível ou usando álcool em gel quando não houver pia disponível.
"Esse hábito interrompe a cadeia de transmissão de muitas infecções, inclusive das bactérias resistentes. Outra medida essencial é o preparo adequado dos alimentos, garantindo limpeza de utensílios, separação entre carnes cruas e outros alimentos e cozimento completo, o que reduz a chance de contaminação por bactérias de origem alimentar",
diz.
Outra coisa importante é evitar o uso desnecessário de antibióticos, uma vez que o gerenciamento mal feito dos medicamentos podem contribuir para o fortalecimento desses microrganismos.
"Nunca se deve tomar por conta própria nem interromper o tratamento antes do tempo prescrito, porque isso favorece o desenvolvimento de resistência", diz.
"Para pessoas saudáveis, o risco de infecções por superbactérias fora do ambiente hospitalar é baixo, mas essas atitudes de cuidado coletivo reduzem a circulação desses microrganismos e ajudam a preservar a eficácia dos antibióticos para quando realmente forem necessários", adiciona.
Nos últimos anos, as mudanças climáticas têm contribuído, mesmo que indiretamente, para a disseminação das superbactérias. O infectologista explica que as temperaturas mais altas, períodos de chuva intensa ou umidade elevada favorecem a multiplicação e sobrevivência de microrganismos em geral.
Mas ele volta a ressaltar que o principal responsável pelo surgimento das superbactérias é o uso indiscriminado e inadequado de antibióticos, bem como a falta de higiene hospitalar, além da globalização e mobilidade internacional, que facilitam o transporte dessas bactérias entre países e continentes.
"Além disso, o uso de antibióticos na agropecuária exerce forte pressão seletiva, permitindo que bactérias resistentes surjam em animais e cheguem até as pessoas pela cadeia alimentar" , adiciona.
Importância das políticas públicas
De acordo com Alexandre Naime, as políticas públicas desempenham um papel essencial no enfrentamento das superbactérias, porque abrangem diferentes pontos da cadeia que favorece o surgimento e a disseminação da resistência.
O saneamento básico, por exemplo, ajuda a reduzir e a prevenir as doenças infecciosas transmitidas pela água e por alimentos contaminados.
"Ao evitar esses quadros, diminui-se a procura por antibióticos, sobretudo em regiões onde o uso indiscriminado ainda é frequente. Além disso, saneamento adequado reduz a circulação de microrganismos resistentes no ambiente, incluindo aqueles originados de resíduos hospitalares e comunitários",
diz.
Outro ponto fundamental é a vacinação. Segundo o infectologista, as vacinas ajudam a reduzir a incidências de infecções preveníveis, como a pneumonia e a meningite, além de infecções virais respiratórias, como influenza e a COVID-1.
Essas são condições que podem evoluir para pneumonias virais e, em muitos casos, colaborar para pneumonias bacterianas secundárias.
"Ao prevenir essas doenças virais iniciais, as vacinas contribuem indiretamente para diminuir o uso de antibióticos e, consequentemente, reduzem a pressão seletiva que favorece o surgimento e a disseminação das superbactérias"
, diz.
A medida mais decisiva, na visão do infectologista, é a regulamentação do uso de antibióticos.
"Cada vez que um antibiótico é utilizado sem real necessidade, cria-se a oportunidade para que bactérias resistentes sejam selecionadas. Países que adotaram políticas mais rígidas nesse sentido já demonstraram impacto positivo na contenção da resistência antimicrobiana",
diz.
"Vacinação, saneamento e regulação do uso de antibióticos formam um tripé essencial: evitam doenças que levariam ao uso desnecessário de antibióticos, reduzem a exposição a microrganismos resistentes e preservam a eficácia dos medicamentos que ainda temos disponíveis", conclui o especialista.